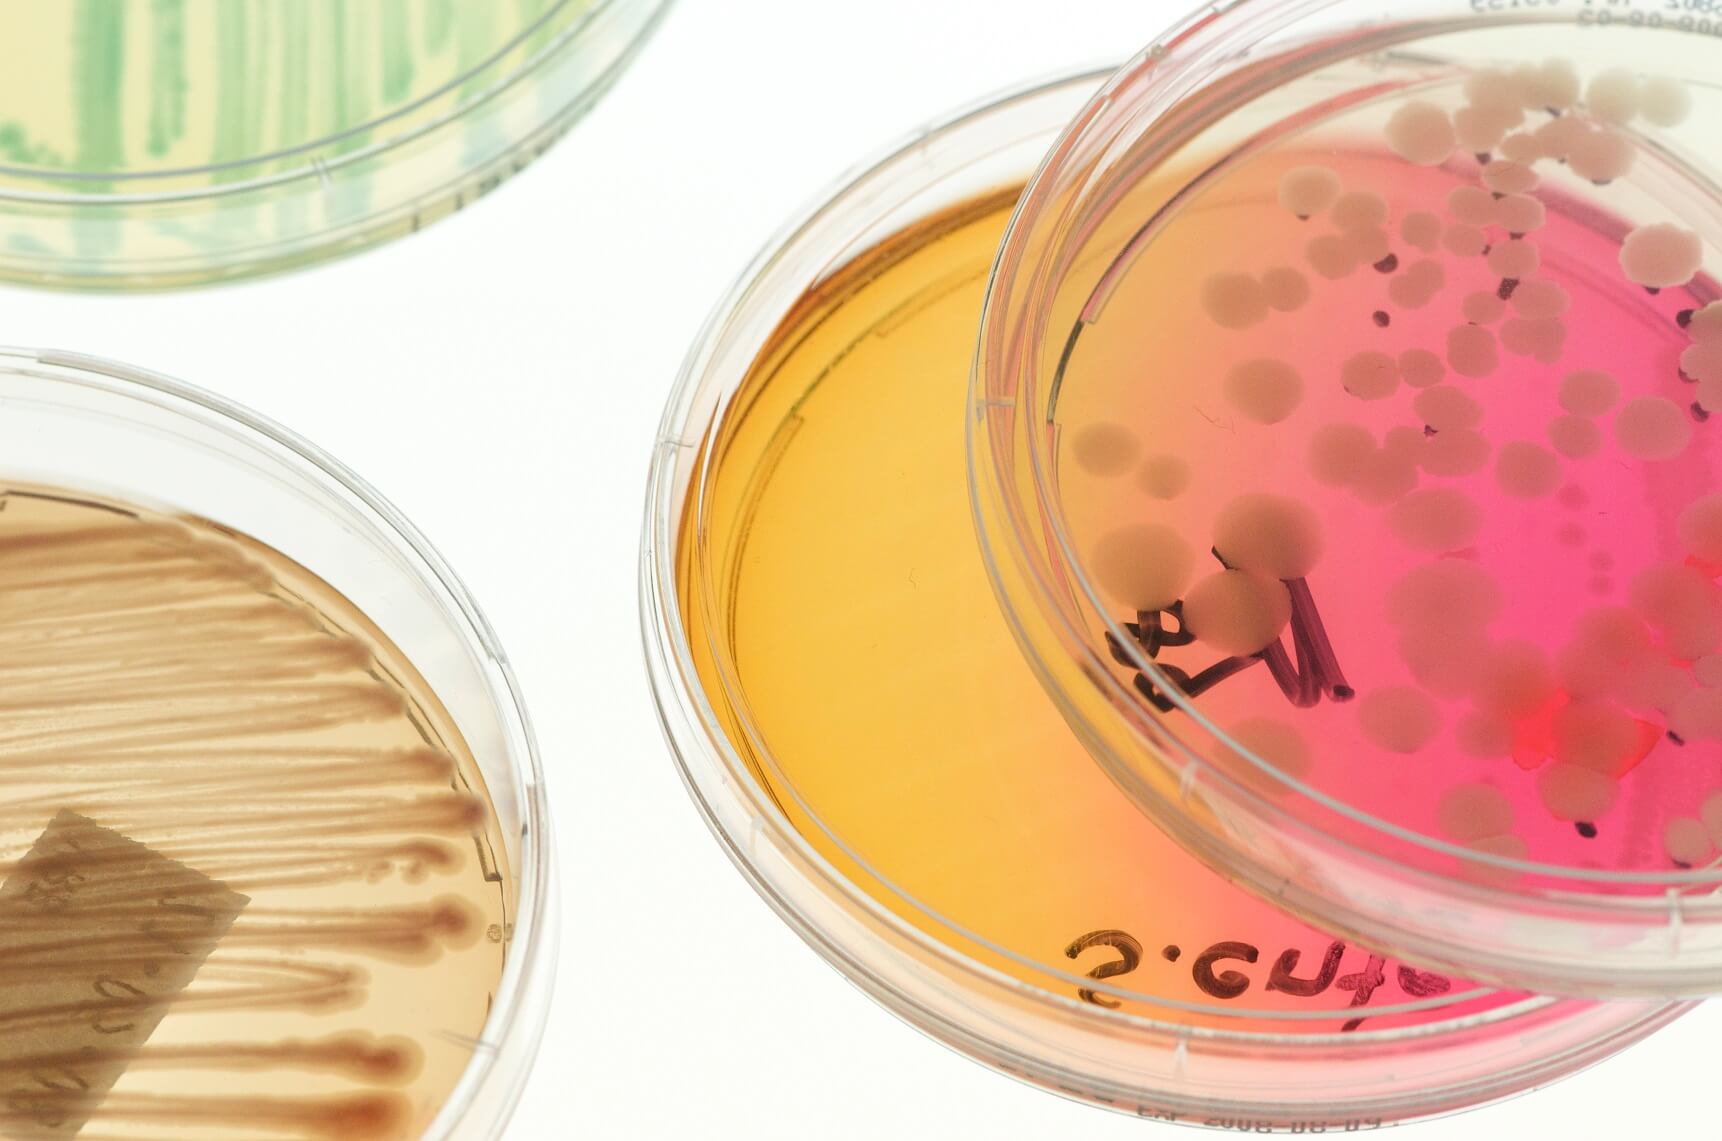

Les Campylobacteraceae sont une famille de bactéries de l'ordre des Campylobacterales.
Genres
Selon List of Prokaryotic names with Standing in Nomenclature :
- Campylobacter Sebald and Véron 1963 (Approved Lists 1980)
- Dehalospirillum Scholz-Muramatsu et al. 2002
- Sulfurospirillum Schumacher et al. 1993
Références
Bibliographie
- George M. Garrity (Hrsg.): Bergey’s Manual of Systematic Bacteriology. volume 2: The Proteobacteria. Part C: The Alpha-, Beta-, Delta-, and Epsilonproteabacteria. Springer, New York 2005, (ISBN 0-387-24145-0).
Liens externes
- Ressources relatives au vivant :
- EPPO Global Database
- Global Biodiversity Information Facility
- iNaturalist
- Interim Register of Marine and Nonmarine Genera
- List of Prokaryotic names with Standing in Nomenclature
- New Zealand Organisms Register
- Système d'information taxonomique intégré
- World Register of Marine Species
- Portail de la microbiologie